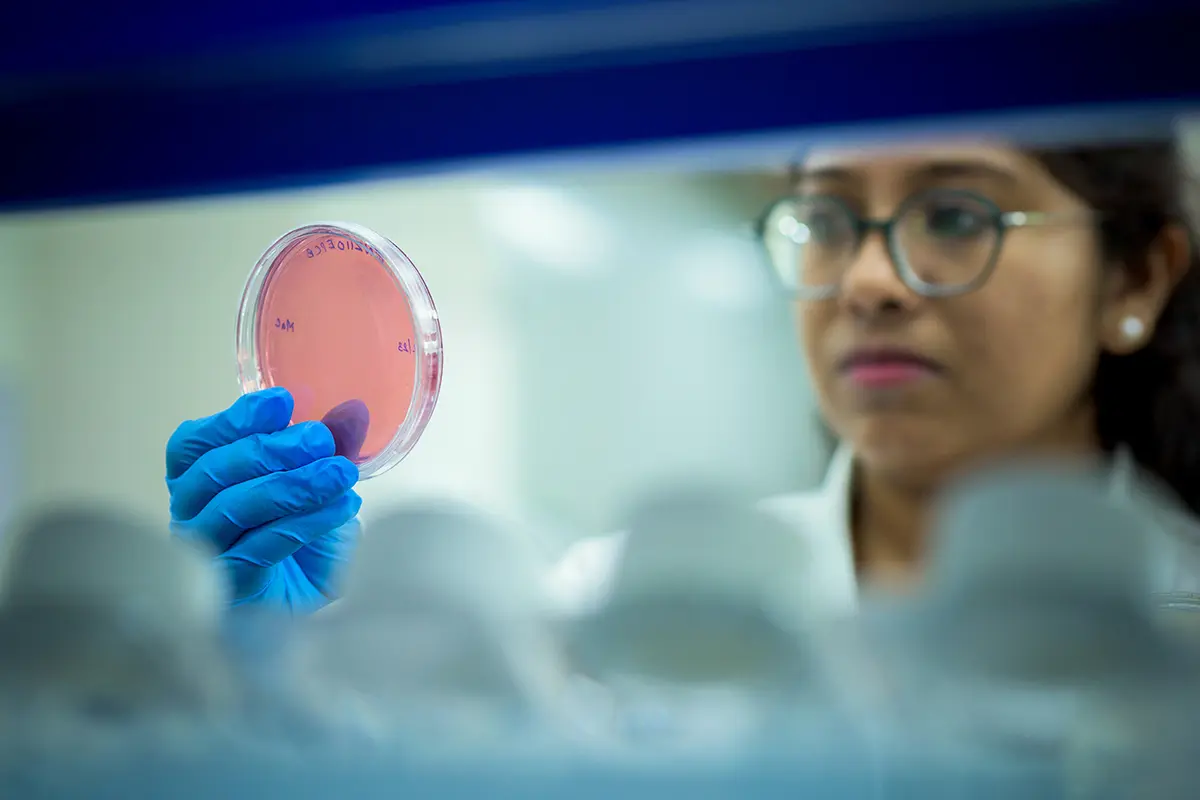

About us
We are a global CDMO and biosimilar developer dedicated to realizing your vision to bring accessible, high-quality treatments to patients around the world. Through a passionately progressive approach designed just for you, our cutting-edge services and productive pipeline of biosimilars cater to your project’s every need.
What do we do?
We are a global specialist in biologics and biosimilars development, manufacturing and supply, dedicated to achieving your goals with uncompromised quality, seamless efficiency and reliable cost-effectiveness.

Our vision, mission and values
Our vision is to transform the landscape of global healthcare with innovative technologies and life-changing treatments.
By creating an unparalleled platform for innovation, we strive to deliver trusted and affordable medicines that enhance quality of life, reshape the pharmaceutical landscape, and ultimately make a positive impact on millions of lives worldwide.
We plan to achieve our vision by committing to innovation, quality, scalability, talent and responsibility.
The future begins now
Your biologic deserves the most technologically advanced manufacturing process in the industry. And you deserve a new way to think about strategic partnership. Today is just the beginning.
